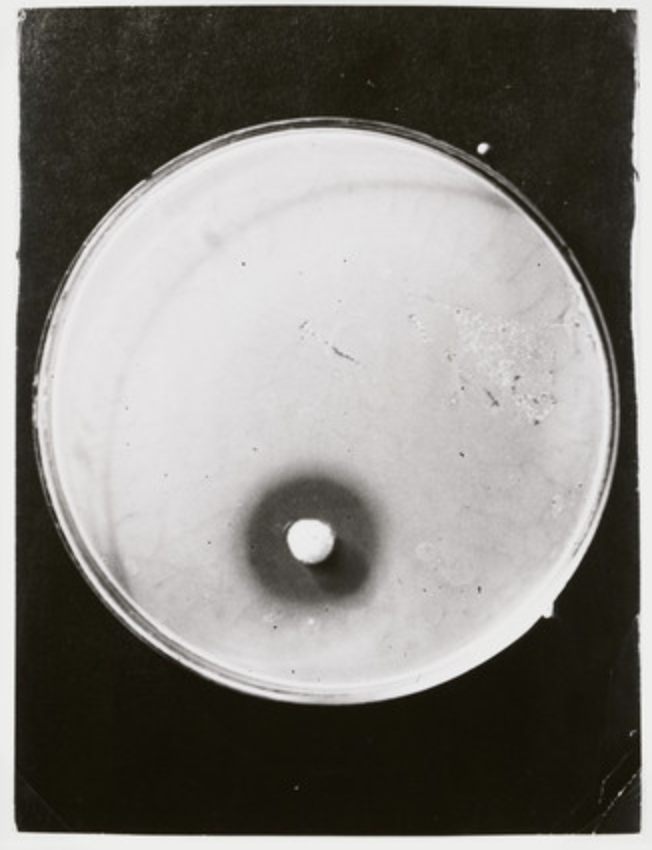

97039: Global Health, Antimicrobial Drugs and Vaccines
Module 2: The crises of new antibiotic development
Russell Lewis, Associate Professor
Infectious Diseases, IRCSS S. Orsola-Malpighi Hospital
Department of Medical and Surgical Sciences
Alma Mater Studiorum
Università di Bologna
Learning objectives
- Discuss factors contributing to the lack of new antibiotic development
- Compare and contrast economic incentives proposed to enhanced antibiotic development
- Examine challenges in ensuring antibiotic access in low and middle income countries (LMICs)
Antibiotic development timeline

source: www.react.org
Increase in numbers of group 1, 2, and 3 beta-lactamases

Bush, K. & Jacoby, G. A. Antimicrobial Agents and Chemotherapy 54, 969–976 (2010).
Global Research and Development Priorities for AMR
| Priority | Pathogens included |
|---|---|
| Critical |
Acinetobacter baumannii (Carbapenem-resistant) Pseudomonas aeruginosa (Carbapenem-resistant) Enterbacterales (3rd generation cephalosporin, carbapenem-resistant) |
| High |
Enterococcus faecium, vancomycin-resistant Staphylococcus aureus, methicillin-resistant, vancomycin intermediate and resistant Helicobacter pylori, clarithromycin-resistant Campylobacter, fluoroquinolone-resistant Salmonella spp., fluoroquinolone-resistant Neisseria gonorrhoeae, 3rd gen. cephalosporin-resistant, fluoroquinolone-resistant |
| Medium |
Streptococcus pneumoniae, penicillin-non-susceptible Haemophilus influenzae, ampicillin-resistant Shigella spp., fluoroquinolone-resistant |
This table does not include Mycobacterium tuberculosis, which was already recognized as a global health priority pathogen
Source:World Health Organization
WHO Clinical Antibiotic Pipeline Report
-
New antibiotic development is driven by small- or medium-sized enterprises (SMEs), with large pharmaceutical companies continuing to exit the field (currently 4 large Pharma companies)
-
Eight new antibacterial agents have been approved since 1 July 2017, but overall, they have limited clinical benefits.
-
One new anti-tuberculosis (anti-TB) agent, pretomanid, developed by a not-for-profit organization, has been approved for use within a set drug-combination treatment for MDR TB.
-
The clinical pipeline remains insufficient to tackle the challenge of increasing emergence and spread of antimicrobial resistance.
Update: Antimicrobial Agent Chemother 2022: 10 January 2022

Why are new antibiotics not being developed?
The scientific challenges of antibiotic discovery
-
Ideally must target multiple pathways in bacterial species (to avoid rapid resistance development) ...but not human targets
-
Must be safe...drugs are administered in grams, not mg or μg
-
Must penetrate and be active in multiple body sites
-
Must be effective now and in the future against resistant pathogens (i.e. predict future resistance problems)-
-
you must be looking now for the antibiotic you will use in 2040!
-
Natural product screening:
The "golden age" of antibiotic discovery before 1965: soil Streptomycetes and fungi

Penicillin culture flasks, 1942. Photo: James Jarche
1970s to 1990s- modified chemistry
to overcome resistance
Since 1970, the only indisputably new antibiotic classes to reach the market are: the oxazolidinones (discovered 1978, launched 2000) and lipopeptides (discovered 1986, launched 2003)
Penicillins → cephalosporins, carbapenems
nalidixic acid → fluoroquinolones
kanamycin → amakacin
glycyclines → tetracyclines
resistance
mechanisms
develop to entire antibiotic classes
Regulatory requirements



United States Food and Drug Administration
EMA

African Medicines Agency
Many other countries have their own processes for drug registration and approval

Antibiotic approval process and expected costs
Costs on average: 1-1.5 billion US dollars
Wouters et al. JAMA 323, 844–853 (2020).
Proving efficacy in humans: The Phase III non-inferiority trial:
A paradoxical problem for antibiotics
-
Medical Priority: We need new drugs for bad bugs
-
The superiority of a NEW antibiotics is easily shown in the lab on the basis of MIC testing (potency) or in animal models of infection
-
-
Clinical data is the problem- trials must (usually) be designed to avoid superiority
-
Example: Limb-threatening skin and soft-tissue infection due to MRSA....It is not ethical to randomize to methicillin vs. NEW Antibiotic, must instead compare vancomycin vs. NEW antibiotic
-
Patients cannot be enrolled in a trial where they are randomized to be treated with an ineffective antibiotic
-
-
Instead we must use non-inferiority designs showing similar activity relative to another active agent
"Assessing non-inferiority in a trial is more complex than assessing superiority, in both the design and analysis phases.
Although it is not statistically possible to prove that two treatments are identical, it is possible to determine that a new treatment is not worse than the control treatment by an acceptably small amount, with a given degree of confidence"ce.
Mauri L, D’Agostino RB Sr. Challenges in the Design and Interpretation of Noninferiority Trials.
N Engl J Med 2017; 377:1357–1367.
A
B
C
D
E
F
G
H
New treatment better
active control better
Absolute Risk
Difference=0
(95% confidence intervals)
Δ inferiority margin (e.g., 10%)
Conclusion from trial
1. Superiority concluded
2. Non-inferior but not superior
3. Non-inferior but possibly not inferior
5. Non-inferiority not shown
6. Non-inferiority not shown
7. Non-inferior but inferior
8. Inferiority concluded
Typical antibiotic Phase III trial: prove an antibiotic is not inferior to "active control therapy" and not 10% worse for study outcome
Approved
Approved
Approved
Approved
Rejected
Rejected
Rejected
Rejected
4. Non-inferior but not superior
"Δ" is a critical decision in the Phase III trial design

-
DPE is the difference in point estimates of response rates for placebo and active therapy. No adjustment is made for the precision of these two estimates.
-
M1 is a margin less than DPE that is thought to be the largest reliable estimate of the treatment effect that incorporates the uncertainty around the individual
-
M2 is a margin less than M1 that is proposed as a clinically acceptable margin and reflects the degree of potential loss of efficacy that is acceptable.
Δ
Np-nosocomial pneumonia
cIAI-complciated intraabdominal infections
cUTI- complicated urinary tract infections
Is it feasible to perform a clinical trial for MDR pathogens?

Statistical examples for a nosocomial pneumonia trial
Typical estimate would be 10-15% of patients in ICUs from large academic medical centers have pathogen of interest, but not necessarily MDR pathogens
Implications: Hundreds of enrolling centers required, huge costs, high risk

Huge costs are also incurred post-approval for antibiotics
Pediatric dosing and safety studies,
Pharmacokinetic studies in special populations (i.e. elderly, obese, dialysis)
Pharmacovigelence (safety)
Development and validation of susceptibility testing technology/platforms
Manufacturing and supply chain investments
5-10 years commitment to monitor resistance through antimicrobial surveillance studies..etc, etc....
How can a company overcome these costs once the antibiotic is approved?
Costs = Antibiotic Price * Units Sold

Business plan: Sell lots of antibiotics (high use → drive resistance → drug becomes less effective) or charge very high prices

Source: Financial Times

McKenna, M. Nature 584, 338–341 (2020).
Typical patent life: 20 years from discovery

McKenna, M. Nature 584, 338–341 (2020).
The Achaogen story (developer of plazomicin)

NY Times December 25, 2019
-
Achaogen a company founded in 2002 developed a new aminoglycoside (plazomicin) that was active against WHO-priority Gram-negatives, including carbapenem-resistant Enterbacteriacea (CRE)
-
Achaogen raised around $500+ million in venture capital and public funds to advance into Phase III trials, not counting non-dilutive support and debt
-
A phase 3 complicated UTI trial was completed in Dec 2016 demonstrated impressive activity vs. meropenem (EPIC trial)
The Achaogen story...
The Achaogen story cont.
-
Allergan and Melinta launched ceftazidime-avibactam and meropenem-vaborbactam in 2015 and 2017 respectively- two beta-lactam antibiotics that cover CRE (competititors to plazomicin)
-
A Phase 3 trial of plazomicin vs. colistin-standard of care in CRE bloodstream infection was started in 2014 (CARE trial) but this trial was difficult to enroll with 2100 patients screened and 37 randomized over 2.5 years at a cost of 70 million.
-
Plazomicin was launched in the U.S. in July 2018
-
Added to the WHO Essential Medicines list
-
Archaogen filed for Chapter 11 bankruptcy in April 2019
-
Cipla Pharmaceuticals buys plazomicin for 16 million
Plazomicin: a major advance, but not approved in Europe

McKinnell, J. A. et al. New England Journal of Medicine, 380(8), 791-793.
Patients receiving plazomicin developed less nephrotoxicity:
16.7% vs. 50%


Manufacturer of meropenem-vaborbactam
What can be done to revive the antibiotic pipeline?

DRIVE-AB 2008
incentive recommendations
- Grants -for antibiotic research and development
- Pipeline coordinators -technical and financial priorities
- Market entry rewards -after successful regulatory approval
- Long term supply/availability- continuity model
"Push incentives" → push out new drugs→ stimulate research and development of new molecules active against priority pathogens
"Pull incentives" → Once you are approved, how will you be rewarded if your drug is on the market?
"Push incentives"
- Early stage funding → antibiotic discovery, early clinical trials
- Occur before regulatory approval by regulatory agency
- Supports many projects, including antibiotics that fail before approval
-
US Biomedical Advanced Research and Development Authority BARDA (1.2 billion dollars to support Phase 2/3 antibiotic development against 21st century threats including drug-resistant bacteria, supports CARB-X)
-
CARB-X (550 million, Hits to lead Phase 1 product development of therapeutics, diagnostics and preventatives against WHO and CDC priority drug-resistant bacteria)
-
The Global Antibiotic Research and Development Partnership -GARDP (Produce discovery from discovery to delivery including novel therapeutics, optimizing antibiotics, developing combinations. Focused on WHO priority list).
-
Novo Holdings REPAIR Impact Fund (165 million investment in lead optimization to Phase I development of therapeutics and diagnostics against WHO priority drug-resistant bacteria
-
Joint Programming Initiative on Antimicrobial Resistance -JPIAMR (novel therapeutics, diagnostics, surveillance, prevention, stewardship, WHO priority pathogens
Examples of Push Incentives
Examples of Push Incentives, cont.
-
Wellcome Trust (175 million drug-resistant infections focused on policy, strengthening evidence for action, clinical trial capabilities and innovative product development including CARB-X
-
AMR Action Fund. WHO, European Investment Bank, and Wellcome Trust
-
UK AID (315 million pounds funded through the Global AMR innovation fund and the Fleming Fund to help LMICs tackle AMR).
-
The German Federal Ministry of Education and Research support of national research programs as well as contributions to international initiatives like CARB-X, GARDP, and JPIAMR.
-
Bill & Melinda Gates Foundation (124 million targeting drug-resistant infections in low-middle income countries (LMICs), disease surveillance, vaccine development, economic modeling, and CARB-X
-
U.S. National Institutes of Health (1.4 billion dollars funding basic research, academic industry startup partnerships, and other research and development against bacterial threats, for vaccines, therapeutics and diagnostics
Pull incentives

Pull incentives are primarily after regulatory approval and hence only successful products are supported
Pull incentives: the NETFLIX Model

Netflix is a subscription-based streaming service that allows our members to watch TV shows and movies without commercials on an internet-connected device.
You pay a monthly fee whether or not you watch movies.
How would a Netflix-like pull incentive work for antibiotics?
- UK Example: Two antibiotics from a pool of candidates are selected- must be an antimicrobial approved in the last 1.5−3 years, and the other will be a late-stage pipeline product expected to be approved by the end of 2020
- Any company to be considered for the model must have a demonstrated commitment to relevant environmental and access standards as described in the AMR Benchmark
- National Institute for Health and Care Excellence (NICE) performs a cost-effectiveness analysis, then computes a fair "subscription price"
- National Health Service (NHS) England then enters into commercial negotiations with the proprietors of the two selected products to agree on payments, which will take the form of an annual fixed fee of up to £10 million per product
- This maximum annual fee is based on a calculation what approximately England’s “fair share” would be of the proposed US $2−4 billion financial incentive needed, per new antimicrobial, globally, to revitalise the antimicrobial pipeline
How would a Netflix-like pull incentive work for antibiotics?
More detail on antibiotic pull incentives being considered by different countries...

Gotham, D. et al. Health Policy 125, 296–306 (2021)
- Spectrum: Benefits of being able to treat with a narrow-spectrum agent in some settings (note how this use of Spectrum has a very specific meaning).
- Transmission: Benefits from avoiding spread of infection
- Enablement: Benefits from making it safe to receive medical care
- Diversity: Using varied antibiotics reduces resistance pressure
- Insurance: Value of having an antibiotic to hand in case of sudden need
Additional values of antibiotics (STEDI)

Slide: John Rex, M.D.
Antibiotics are the "fire extinguishers" of medicine
- Nobody wishes to put out a fire
- Firefighters perform regular maintenance and training to ensure they are ready 24/7 as a precaution to fight fires
-
We pay firefighters to be available and prepared so they can come to our rescue when we need them
-
We should pay to have antibiotics ready for resistant infections in hopes that we never need them
Lack of antibiotic availability due to supply chain problems

Increasing frequency of shortages for injectable generic antibiotics contributes to antimicrobial resistance

Shafiq, N. et al. BMJ Global Health 6, e006961 (2021).





Antibiotic access in low-middle income countries

The challenge in many LMICs
- Limited access to basic sanitation or healthcare increases the risk and spread of antimicrobial resistance
- Antibiotics, often available without prescription, may be used for substitutes of clean food, water and access to vaccines or diagnostics
- Antibiotic access and resistance cannot be addressed effective without addressing contributing factors

Frost et al. Access Barriers to Antibiotics. Center for Disease Dynamics, Economics & Policy (CDDEP), 2019.
Global antibiotic consumption (2000 to 2015). Change in antibiotic consumption rate per 1,000 inhabitants per day.

Antibiotic consumption rate in defined daily doses (DDDs) per 1,000 inhabitants per day by country in 2015
Defined daily dose (DDD) is a standardised index of drug consumption, defined by the WHO, used to compare antibiotic use between different drug classes and dosage forms.
DDD is calculated by multiplying the quantity field by the DDD conversion factor field. For example, the strength of one ciprofloxacin tablet is 500 mg and the DDD is 1 g (500 mg twice daily) for ciprofloxacin. Each 500 mg tablet is equivalent to 0.5 DDD.
Frost et al. CDDEP, 2019.
Antibiotic access in LMICs:
Barrier 1: Irrational selection and use of antibiotics
- Incentives for sale and inappropriate use of antibiotics- i.e. conflict of interest common such as payments linked to antibiotic prescribed
- Over the counter antibiotic sales
- Frequent prescribing by non-professionals
- Multiple different regulatory agencies- difficult cost justification for registration in many LMICs
Frost et al. CDDEP, 2019.

| CDDEP Recommendation | Stakeholders | Rationale | |
|---|---|---|---|
| 1 | Encourage R&D of new or improved antibiotics, diagnostic tests, vaccines, alternatives to antibiotics for bacterial infections | Countries, regional collaborators, WHO and other international bodies, pharmaceutical industry, academia | At a global scale, higher investment in novel antibiotics, temperature-stable formulations, and rapid diagnostic tests |
| 2 | Support the registration of antibiotics in more countries according to clinical need | WHO and other international bodies, national governments, policymakers, regulators, pharmaceutical industry | Efforts at the national, regional, and global levels to support drug registration could reduce the upfront cost of accessing less attractive markets and benefit patients by making life-saving drugs available. Newer drugs coming to market are likely to be introduced by small and medium-size enterprises that may not have the expertise or resources to register in multiple countries. However, this cost should not be a barrier. |
| Regulators and policymakers | In many instances, regulations and requirements could be aligned across countries and simplified to reduce costs | ||
| Pharmaceutical companies | Plans for registration should be part of the development process. |

| CDDEP Recommendation | Stakeholders | Rationale | |
|---|---|---|---|
| 3 | Establish standards of practice and national treatment guidelines. | WHO, countries, experts and their professional associations, hospitals and community care facilities | The WHO should issue a call to action for all professional associations and councils involved in prescribing practices to develop clinical guidelines for treating infectious diseases at all levels of healthcare. |
| 4 | Generate awareness and educate patients and prescribers. | Non governmental organizations (NGOs), advocacy groups, professional bodies,WHO offices at all levels, health ministries, and local institutions (hospitals, clinics, schools, churches, etc.) | Information about the price and quality of antibiotics approved for use in a country will support rational prescribing and use, as will surveillance data on local antibiotic resistance profiles. NGOs, professional bodies, and advocacy groups can use existing communications channels to educate patients and prescribers about drug quality and rational antibiotic use. Such information will empower consumers who purchase drugs out-of-pocket to demand quality antibiotics while increasing price competition among suppliers and removing poor-quality suppliers from the market. |






| CDDEP Recommendation | Stakeholders | Rationale | |
|---|---|---|---|
| 5 | Reduce conflict of interest and incentives that lead to inappropriate antibiotic use. | Regulators, NGOs, doctors, and patients | Conflicts of interest between prescribers and the vendors of pharmaceuticals can be addressed by regulating gifts from drug companies and promoting the enforced or voluntary declaration of such gifts |



Progress in regulation and rationale use
Barrier 2: Antibiotics are not affordable for many in LMICs and government funding for health is low
- Less than 10% of public spending in many LMICs goes to healthcare
- Less than half of essential medicines are available in many countries

| CDDEP Recommendation | Stakeholders | Rationale | |
|---|---|---|---|
| 6 | Explore innovative funding of essential antibiotics | UNICEF, WHO, national governments, pharmaceutical manuscfactures | Countries with less purchasing power could pool their resources for procurement under arrangements similar to Gavi (the vaccine alliance) or the Global Fund. UNICEF/WHO might coordinate procurement and distribution. Besides helping LMICs increase their purchasing power, such an arrangement would support quality manufacturers while driving out substandard suppliers. |
See online resources for discussion of these programs

Barrier 3: Weak health systems, unreliable supply chains and poor quality-control fail to deliver antibiotics to patients in need
- Out-of-pocket payments for antibiotics either limit access or push people further into poverty
- In remote areas, transportation costs and accompanying relatives may be unaffordable
- Antibiotics are often not available or may be of poor quality

| CDDEP Recommendation | Stakeholders | Rationale | |
|---|---|---|---|
| 7 | Ensure the quality of antibiotics, and strengthen pharmaceutical regulatory capacity | WHO, national and regional regulators, countries, pharmaceutical suppliers and manufacturers | WHO support and coordination, national and regional regulators could collaborate to support quality assurance and avoid duplication of effort across countries; Rapid information exchange for pharmacovigilance, information on poor- quality suppliers, and sharing of best practices and innovation will help drive substandard and falsified antibiotics from the market. An international entity, such as the WHO, could provide surveillance, monitoring, and compliance testing for antibiotic quality. Such work would support LMICs' regulatory authorities and also ensure the integrity of the supply chain from the dominant suppliers in India and China. It could also establish standards for generic antibiotics and fixed-dose combinations, which are commonly used in LMICs, and support the industry in self- regulation. |
| CDDEP Recommendation | Stakeholders | Rationale | |
|---|---|---|---|
| 8 | Encourage local manufacturing for cost-effective antibiotics. | Countries, regional collaborations, pharmaceutical industry, including drug R&D and manufacturers | Development and diversification of local manufacturers can help ensure the steady supply of essential, quality-assured antibiotics so that countries can meet their own needs. This should be supported through regional collaborations of countries such as the African Union. |

Summary
- Both scientific and economic challenges has caused many companies abandon development of new antibiotics
- The depleted antibiotic pipeline and increasing resistance has major public health implications for medicine in both high-income and low-income countries
- While antibiotic overuse is the major concern in high-income countries, access to effective and affordable antibiotics in many LMICs is inadequate but increasing with less infrastructure to support rationale use
Group exercises
- Evaluate a new antibiotic (X-1) for approval of Pseudomonas aeruginosa infections
Module 2: Crises in New Antibiotic Development
By Russell Lewis
Module 2: Crises in New Antibiotic Development
Module 1. 97039-Global Heath, Antimicrobial Drugs and Vaccines
- 474